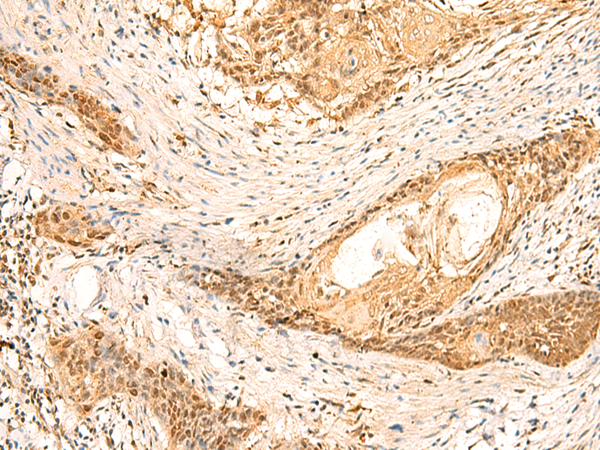

中文名稱:兔抗EEF1AKMT2多克隆抗體
|
Background: |
Protein-lysine methyltransferase that selectively catalyzes the trimethylation of EEF1A at 'Lys-318'. |
|
Applications: |
ELISA, IHC |
|
Name of antibody: |
EEF1AKMT2 |
|
Immunogen: |
Fusion protein of human EEF1AKMT2 |
|
Full name: |
EEF1A lysine methyltransferase 2 |
|
Synonyms: |
Efm4; METTL10; C10orf138 |
|
SwissProt: |
Q5JPI9 |
|
ELISA Recommended dilution: |
5000-10000 |
|
IHC positive control: |
Human prostate cancer and Human esophagus cancer |
|
IHC Recommend dilution: |
50-300 |
購物車
幫助
021-54845833/15800441009
